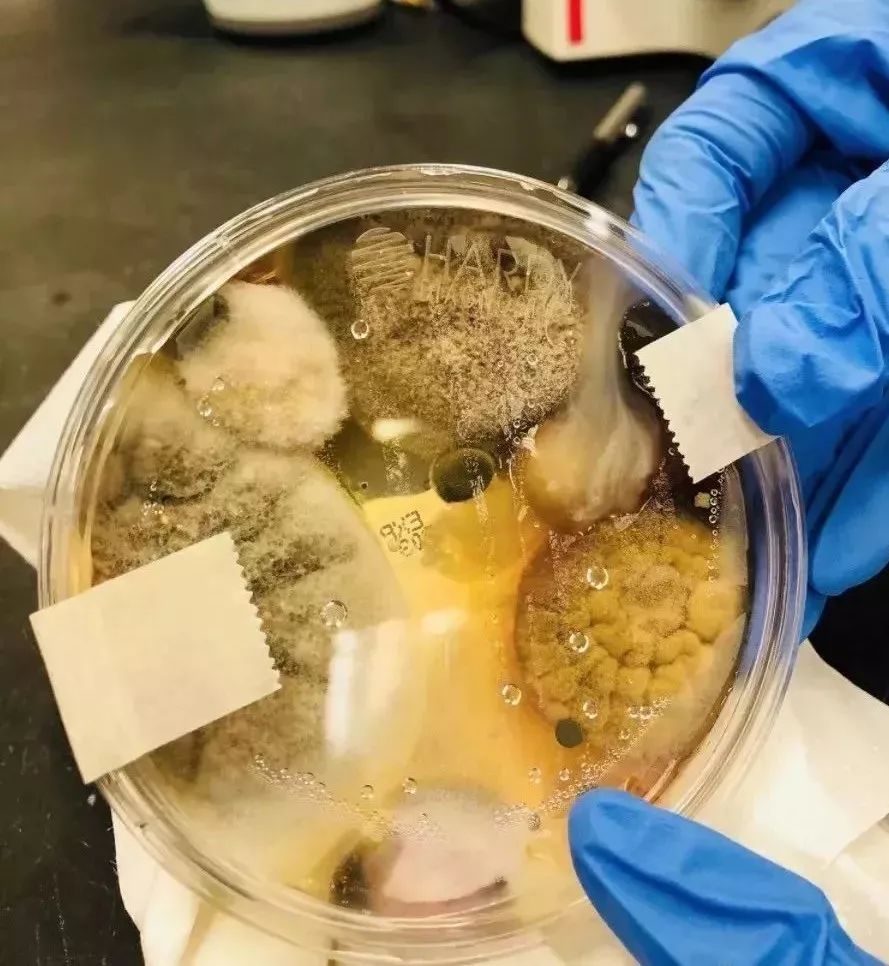
看似干净的东西原来这么脏！做到这几点，孩子少生病

过敏大概是现代孩子最基本的「文明病」,而现在人外食居多,假日商场百货更是人满为患,公共场所里,到处是细菌的温床!
有些你觉得干净的地方其实脏的很!

公厕到底有多“脏”?
相信很长带孩子上完商场、餐厅或公园里的公厕,都要用洗手液仔细洗手,洗完手再用烘干机吹干...生怕不干净,传染疾病。
然而这些常用的“消毒杀菌”洗手法,真的能让孩子远离病菌吗?恐怕你要失望了。
⭐ 1、洗手液:细菌超标上千倍
你知道吗?一些公共卫生间里提供洗手液,并不具有杀菌效果,相反是细菌的温床。

央视记者曾对北京很多商场和餐厅的卫生间进行了采样,结果实验发现:多公共场所的洗手液细菌超标竟然达到10000倍以上!
中国疾病预防控制中心环境所副主任技师李涛表示:

“如果用这么脏的洗手液洗手,轻的话会对手上的创面产生化脓感染;严重的话会产生败血症、菌血症、菌毒血症等,甚至危及生命!”
⭐ 2、烘干机:越吹越脏
烘干机是节约纸张保护资源的很好替代品,但究竟是不是干净健康呢?
国外研究人员做了一个 试验 :
把一个干净的底盘放进公共洗手间的一个烘干机里,放进去了三分钟,然后去做细菌培养,短短48小时,培养皿里疯狂生长出来这些东西:
这些烘干机中有克雷伯氏菌,可能会引起发热、恶心、呕吐;有阴沟肠杆菌,可能导致严重的呼吸道感染。
他们甚至在一个洗手间的烘干机上发现了金黄色葡萄球菌,如果手上有伤口又恰好用了这个烘干机,非常有可能会导致严重的皮肤感染。

有人专门比较了公共洗手间的纸巾、暖风干燥机和喷气式干燥机(纯靠风力吹干手的那种)到底哪个更卫生一些。
结果发现,纸巾是最干净的!
⭐ 3、公共马桶:传播这些病病菌
虽然大家都已经知道,使用用公共马桶不会染性病,但公共马桶可能传播其它疾病,马桶圈会存在如下病菌:
● 诺如病毒——可引起腹泻;
● 大肠杆菌——致病性大肠杆菌可引起腹泻;
● 痢疾杆菌——可引起细菌性痢疾;
● 皮肤病——如脓疱疮、体股癣、丘疹等。

因此相比于马桶,蹲坑可以避免与马桶圈直接接触,在一定程度上减低了致病菌的传播几率。
⭐ 4、免洗洗手液:不如洗手
有些看似人性化的公厕会有免洗洗手液,很受带娃的家长青睐,但熊猫君不推荐用免洗洗手液替代洗手。

免洗洗手液含有杀菌(醇类为主)和护肤成分,但由于里面消毒成分往往具有一定刺激性,尽管含有护肤成分,但还是可能造成皮肤过敏反应。
如何“安全”上公厕?
虽然公厕的卫生状况实在堪忧,但出门在外,不可能让娃憋全程,如何尽可能减少公厕带来的“伤害”呢?
熊猫君给大家提几个 建议 ,供参考:
⭐ 1、上公厕正确洗手姿势
一般来说,洗手的话,用流动水冲洗,最好用香皂,然后用干净纸巾擦干。
如果没有香皂,那就只用清水冲洗,最好冲 40~60秒 ,冲完后再用干净纸巾擦干!

⭐ 2、坐便一定要垫纸
当然尽量选择蹲坑,如遇坐便器,可以用消毒纸巾擦擦再用,或使用一次性马桶垫,也可以铺一圈纸在马桶垫上,总之不要直接接触“污渍”。
⭐ 3、不要中途冲厕所
因为各类致病菌还可能存在于冲马桶时溅起的水滴中。中途冲厕所,这些水滴就有可能经由阴道、肛门和尿道进入体内。
所以,如厕完毕、盖上马桶盖再冲水。
另外,可以带上一叠自粘便签,遇到自动冲水的感应装置,把开关挡住。如果忘带,可以用手把它罩住,直到孩子上完厕所离开。

⭐ 4、使用残疾人卫生间
孩子3岁左右就会产生性别意识,这时最好不要带孩子去异性卫生间,如果是异性父母带的话,可以去残疾人卫生间,最好不要让娃就地解决!
带着孩子更要讲公德,这样才能为TA们做好示范。
摸过公共场所这几样东西,快洗手
① 菜单
到底有多少人摸过,前一个人有没有感冒,或是店员用不洁的抹布擦过,其实真的不知道,而且应该没有定期消毒吧!

② 餐桌上附的调味料罐
盐罐、胡椒粉,蕃茄酱…,吃饭总少不了加点料,店家要固定清洁每一个瓶子,其实应该很难。

③ 饮料上的装饰品
樱桃、柠檬片,这些可能都藏有大肠杆菌,建议不要配着吃。

④卖场手推车
卖场手推车的细菌含量,只少于洗手间…!千万别让孩子坐在里面然后又吃东西!

⑤ 手扶梯把手、电梯按键
这二个看不见的细菌传染力是最快的。尤其是密闭的电梯内。

建议父母只要外出,身上准备消毒酒精、湿纸巾,最好改掉孩子吃手的习惯。
最后,点个【转发】让更多人看到,孩子总生病可能就是这些原因!
